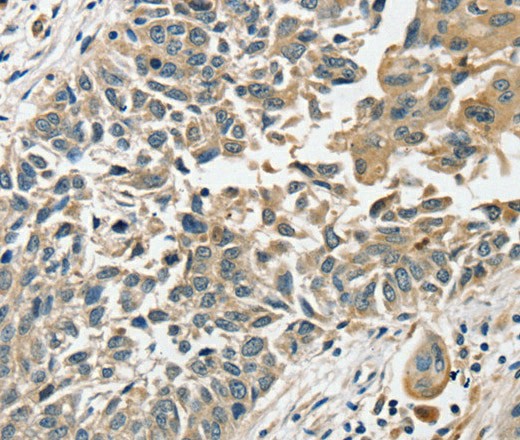
Валидация Elabscience E-AB-16847

| UNIPROT | P57103 |
| Иммуноген | Синтетический пептид, соответствующий человеческому SLC8A3 |
SLC8A3 Polyclonal Antibody (E-AB-16847)
Реактивность подтвержденная:
человек, крыса
Источник (хозяин):
кролик
Валидировано для:
IHC
Характеристики
Техническое описание
| Каталожный номер | E-AB-16847 |
| Название антигена | Solute Carrier Family 8, Member 3 (SLC8A3) |
| UNIPROT | P57103 |
| Иммуноген | Синтетический пептид, соответствующий человеческому SLC8A3 |
| Английские синонимы | NCX3, Na(+)/Ca(2+)-exchange protein 3, Sodium/calcium exchanger 3 |
Реактивность подтвержденная Нужна другая реактивность? |
человек, крыса |
| Источник (хозяин) | кролик |
| Изотип | IgG |
| Клональность | поликлональное |
| Рекомбинантное | нет |
| Готовое к использованию | нет |
| Концентрация | 0.5 мг/мл |
| Конъюгат | нет |
| Валидировано для | IHC Иммуногистохимия |
| Рекомендуемые разведения | IHC 1:25-1:100 |
| Метод очистки | Аффинная хроматография |
| Состав буфера | PBS с 0.05% азид натрия и 50% глицерин, PH7.4 |
| RRID | AB_536989 |
| Условия доставки | термобокс с аккумуляторами холода |
| Условия хранения | Хранить при -20°C - 12 месяцев. Избегать повторяющихся циклов замораживания/оттаивания |
| Срок хранения | 12 месяцев |
| Производитель | Elabscience |
| Ссылка на страницу товара на сайте производителя | https://www.elabscience.com/p-slc8a3_polyclonal_antibody-e_ab_16847 |
|
Артикул
|
Наименование |
Производитель
|
|---|
|
Артикул
|
Наименование |
Производитель
|
|---|
Акции и предложения
Популярные продукты:
Guinea Pig Cytochrome P450 7A1 ELISA kit (E05C0375)
Организм: морская свинка
Recombinant Pseudomonas CopC Protein, N-GST & C-His (YXX20701)
Источник (хозяин): E.coli
Организм: бактерии
Фрагмент: His25-Gln121
Теги: N-GST & C-His
Биоактивность: нет
Организм: бактерии
Фрагмент: His25-Gln121
Теги: N-GST & C-His
Биоактивность: нет
Purified Anti-Mouse MHC II (I-A/I-E) Antibody[M5/114] (FCE1349)
Источник (хозяин): крыса
Реактивность подтвержденная: мышь
Валидировано для: FCM
Реактивность подтвержденная: мышь
Валидировано для: FCM
SLC8A3 Polyclonal Antibody (E-AB-16847)
Источник (хозяин): кролик
Реактивность подтвержденная: человек, крыса
Валидировано для: IHC
Реактивность подтвержденная: человек, крыса
Валидировано для: IHC
HSD17B10 Polyclonal Antibody (E-AB-60967)
Источник (хозяин): кролик
Реактивность подтвержденная: человек, мышь, крыса
Валидировано для: IF, IHC
Реактивность подтвержденная: человек, мышь, крыса
Валидировано для: IF, IHC